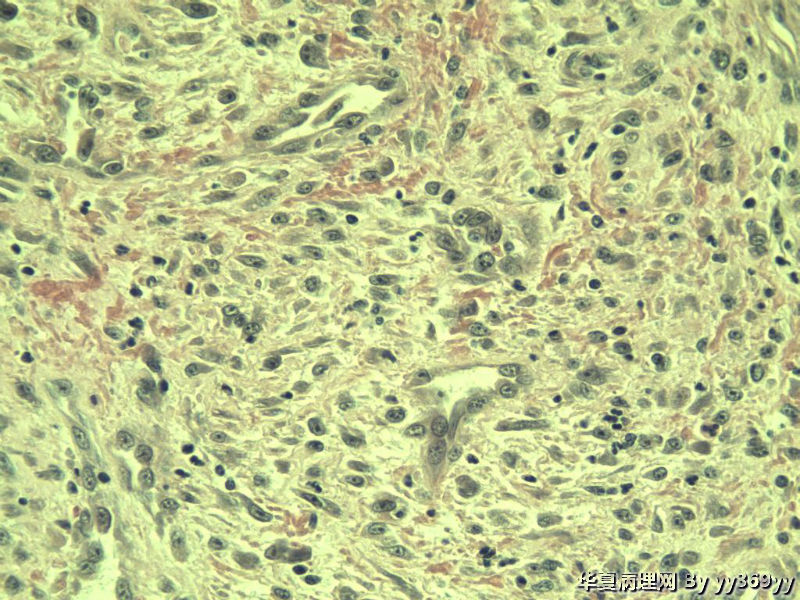
小肠肿瘤图11

| 图片: | |
|---|---|
| 名称: | |
| 描述: | |
- 小肠肿瘤
男 30岁 小肠一段,肠管严重粘连可见一体积为 2.5 × 2 × 1.5 cm3的肿块,切面灰白,实性,质中
请问各位老师,是什么? 谢谢了!
名称:图1
描述:a553.Jpg
名称:图2
描述:a554.Jpg
名称:图3
描述:a555.Jpg
名称:图4
描述:a556.Jpg
名称:图5
描述:a557.Jpg
名称:图6
描述:a558.Jpg
名称:图7
描述:a559.Jpg
名称:图8
描述:a560.Jpg
名称:图9
描述:a561.Jpg
名称:图10
描述:a562.Jpg
名称:图11
描述:a563.Jpg
名称:图12
描述:a564.Jpg
名称:图13
描述:a565.Jpg
名称:图14
描述:a566.Jpg
名称:图15
描述:a567.Jpg
名称:图16
描述:a568.Jpg
名称:图17
描述:a569.Jpg
名称:图18
描述:a570.Jpg
名称:图19
描述:a571.Jpg
名称:图20
描述:a572.Jpg
名称:图21
描述:a573.Jpg
名称:图22
描述:a580.Jpg
名称:图23
描述:a581.Jpg
名称:图24
描述:a583.Jpg
名称:图25
描述:a584.Jpg
名称:图26
描述:a585.Jpg
名称:图27
描述:a586.Jpg
名称:图28
描述:a574.Jpg
名称:图29
描述:a575.Jpg
名称:图30
描述:a576.Jpg
名称:图31
描述:a577.Jpg
名称:图32
描述:a578.Jpg
名称:图33
描述:a579.Jpg
请问各位老师,是什么? 谢谢了!

名称:图1
描述:a553.Jpg

名称:图2
描述:a554.Jpg

名称:图3
描述:a555.Jpg

名称:图4
描述:a556.Jpg

名称:图5
描述:a557.Jpg

名称:图6
描述:a558.Jpg

名称:图7
描述:a559.Jpg

名称:图8
描述:a560.Jpg

名称:图9
描述:a561.Jpg

名称:图10
描述:a562.Jpg
名称:图11
描述:a563.Jpg

名称:图12
描述:a564.Jpg

名称:图13
描述:a565.Jpg

名称:图14
描述:a566.Jpg

名称:图15
描述:a567.Jpg

名称:图16
描述:a568.Jpg

名称:图17
描述:a569.Jpg

名称:图18
描述:a570.Jpg

名称:图19
描述:a571.Jpg

名称:图20
描述:a572.Jpg

名称:图21
描述:a573.Jpg

名称:图22
描述:a580.Jpg

名称:图23
描述:a581.Jpg

名称:图24
描述:a583.Jpg

名称:图25
描述:a584.Jpg

名称:图26
描述:a585.Jpg

名称:图27
描述:a586.Jpg

名称:图28
描述:a574.Jpg

名称:图29
描述:a575.Jpg

名称:图30
描述:a576.Jpg

名称:图31
描述:a577.Jpg

名称:图32
描述:a578.Jpg

名称:图33
描述:a579.Jpg
上面几张图是淋巴结
标签:
-
本帖最后由 yy369yy 于 2012-01-22 18:35:50 编辑
×参考诊断
-
flj20092049 离线
- 帖子:212
- 粉蓝豆:9
- 经验:470
- 注册时间:2011-11-23
- 加关注 | 发消息
-
kangwang2010 离线
- 帖子:389
- 粉蓝豆:13
- 经验:590
- 注册时间:2010-03-04
- 加关注 | 发消息
-
zhenshijian 离线
- 帖子:1069
- 粉蓝豆:91
- 经验:1364
- 注册时间:2008-04-20
- 加关注 | 发消息





























